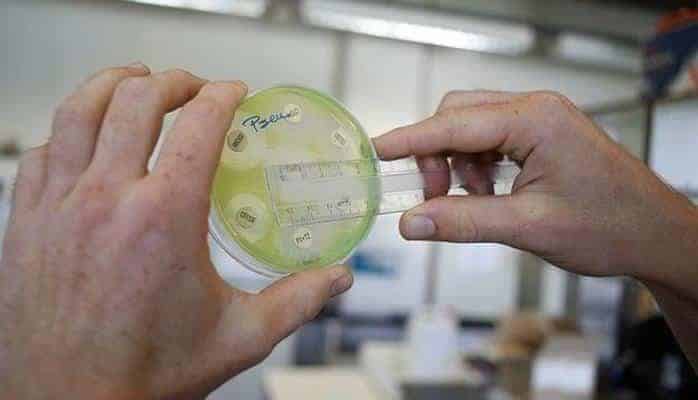

Antibiotikləri özünüzü yaxşı hiss edənə qədər qəbul edin
Böyük Britaniyada bir qrup tibb mütəxəssisi geniş yayılmış fikirlərin əksinə olaraq müalicə zamanı təyin edilən antibiotiklərin sona qədər qəbul edilməsinin faydalı olmadığı barədə xəbərdarlıq edib.
Aralarında Oxford universitetinin elm adamlarının da olduğu mütəxəssislərin fikrincə, xəstələrə antibiotikləri "özlərini yaxşı hiss edənə qədər istifadə etmələri" tövsiyyə edilməlidir.
Lakin bəzi mütəxəssislər isə dərmanın miqdarı ilə bağlı qərarın xəstənin verməsinin lazım olduğunu, nəticələri mənfi ola biləcək "qarışıqlıqlar" yarada biləcəyi barədə xəbərdarlıq da edib.
Böyük Britaniyanın Daily Telegraph qəzetinin manşetində yer alan xəbərə görə, bu mütəxəssislər həddən artıq antibiotikdən istifadənin antibakterial müqavimət yaradacağını müəyyən ediblər.
Dünya Səhiyyə Təşkilatının mövcud hesabatında antibiotiklərin başqa qüvvətli xəstəliklərin yaranmasının qarşısını almaq üçün reseptdə olduğu kimi istifadə olunması tövsiyyə olunur.

"Bu fikrin artıq dilə gətirilməməsinə çağırırıq"
British Medical Journal-da ortaq bir məqalə dərc edən 10 mütəxəssis antibiotikin istifadəsi barədə mövcud fikirlərin elmi dəlillərə əsaslanmadığını və buna son verməyin lazım olduğunu müdafiə edib.
Məqaləyə imza atan mütəxəssislərə görə, antibiotiklə bağlı mövcud istifadə tövsiyyəsi antibakterial müqavimət yarada biləcəyi səbəbiylə insanların sağlamlığını daha çox riskə atır.
Bringhton və Sussex medical School-da yolxucu xəstəliklər üzrə mütəxəssis olan professor Martin Llewelyn "Antibiotiklərin reseptdə olduğu kimi istifadəsinin yaratdığı narahatlıq, qeyri-məqbul müalicənin yaratdığı narahatlıqdan arxada qalırdı" deyir.
Məqaləni yazan Llewelyn fikirlərinə belə davam edib:
"Antibiotik müalicəsinin erkən yekunlaşdırılmasının "antibiotik müqavimət" yaradacağı fikri dəlillərə əsaslanmır. Əksinə antibotiklərin lazım olduğundan artıq istifadəsi müqavimət yaratma riskini artırır".
"Həkimlərə, təlimçilərə və ictimai səhiyyə nümayəndələrinə səslənirik, antibiotikləri sona qədər istifadə etmək barədə fikirləri artıq söyləməyin", o deyib.
"Penisilindən istifadə edirsinizsə, sona qədər istifadə edin"
Antibiotiklərdən istifadənin erkən sonlandırılmasının daha təhlükəli xəstəlikləri yarada biləcəyi fikri penisilini icad edən şotlandiyalı bakterioloq Alexander Fleming-yə qədər gedib çıxıb.
Fleming 1945-ci ildə Nobel mükafını qəbul etdiyi çıxışında "Penisilindən istifadə edirsinizsə, sona qədər istifadə edin" demişdi.
Bu fikrə qarşı çıxan 10 mütəxəssisin fikrincə isə, bir xəstənin antibiotikdən istifadə etməyə başlaması dəridə və mədədə daha sonra problem yarada biləcək bakteriyaların yaranmasına imkan verir.
İstifadə müddəti uzandıqca bu müqavimət də artır. Böyük Britaniyada rəsmi rəqəmlərə görə, hər il ən azı 12 min nəfər antibiotiklərə qarşı müqavimət qazanan mikroblardan həyatını itirir.
Lakin Royal College-dən olan həkimlər xəstələrin özlərini yaxşı hiss etdikləri zaman dərman qəbulunu saxlaya biləcəkləri istiqamətində fikirlərin "qarışıqlıq yarada biləcəyindən" narahat olduqlarını da dilə gətiriblər.
"Xalqa verilən mesaj hələki dəyişməməli"
Royal College-də rəhbər vəzifədə olan professor Dr. Helen Stokes-Lampard antibiotiklərin istifadə miqdarının insana görə təyin edildiyini söyləyərək "Çox zaman istifadə müddəti son dərəcə qısa olur.
Misal üçün, sidik yolları iltihabında 3 gün müalicə kifayətdir " deyir.
Böyük Britaniyada hökumətin səhiyyə sahəsində ən yüksək nümayəndəsi Sally Davies isə xalqa verilən mesajın gələcək araşdırmalar yekunlaşana qədər dəyişdirməmək lazım olduğunu açıqlayıb.
Mütəxəssislər vərəm kimi xəstəliklərin müalicəsində uzunmüddətli antibiotikdən istifadənin son dərəcədə əhəmiyyətli olduğunu bildiriblər.
Mənbə: BBC Azərbaycan





























Şərhlər
Şərhləri göstər Şərhləri gizlət